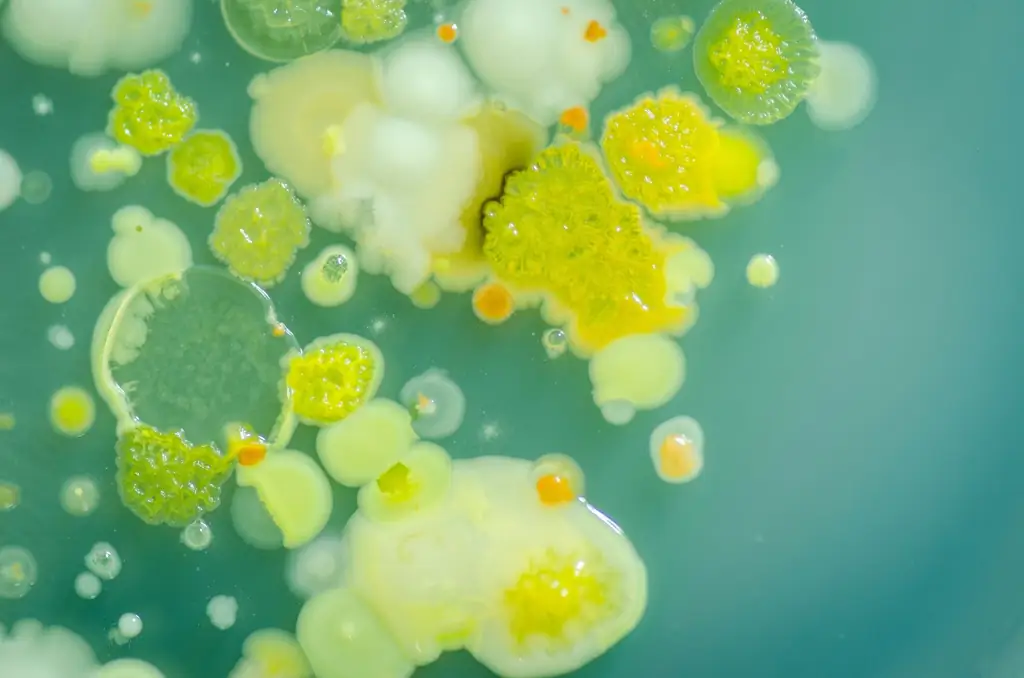
Image

Мир бактерий
Все микроорганизмы мира перечислены в одном большом каталоге: почему трое ученых посвятили себя почти невыполнимой задаче.

"Предполагая, что у вас есть неограниченные средства, как бы вы провели исследование, чтобы идентифицировать от одного до двух триллионов видов?" Такой вопрос задал профессор Джек Гилберт из Чикагского университета на конференции по микроорганизмам. «Из 30 или 40 участников двое проявили огромный интерес», - говорит Гилберт. Это были профессор Роб Найт из Калифорнийского университета в Сан-Диего и Джанет Янссон из Тихоокеанской северо-западной национальной лаборатории в Ричленде. С тех пор все трое вместе занимаются проектом «Микробиом Земли» и ставят своей целью каталогизацию всех микроорганизмов на планете.
Изначально Гилберт был экспертом по бабочкам. Он пришел к микроорганизмам через мороженое. В 2004 году крупная компания наняла его для исследования белков-антифризов в Антарктиде, чтобы сделать мороженое более мягким, и эти белки были обнаружены в бактериях. Отсюда резюме Гилберта приняло неожиданный оборот: «Я увидел разнообразие бактерий в озерах, и это было просто завораживающе», - вспоминает ученый.
Поэтому он стал доктором микробиологии и с тех пор посвятил себя микроорганизмам - будь то те, что находятся под подошвами обуви или в кишечнике пациентов, которые только что перенесли операцию. В своем университете в Чикаго он является адъюнкт-профессором кафедры экологии и эволюции и кафедры хирургии. В то же время он занимает еще две должности. Но он считает свой последний проект новаторским для науки - да, для человечества. На первый взгляд глобальное изучение микроорганизмов кажется абсолютно бессмысленным.
Это первая часть нашей серии о последних белых пятнах на Земле
Другие части выйдут в ближайшие несколько недель.
Потому что маленькие существа повсюду: резвятся на клавиатуре компьютера, в кишечнике, во рту и в носу. Они живут в морских глубинах, во льдах полярных регионов, на растениях, животных, скалах и даже в воздухе. Известны даже не все организмы, колонизирующие человеческий организм. А чайная ложка почвы может вместить 100 000 бактерий, не считая остальных микроорганизмов.
Способны на самые невероятные вещи
На самом деле термин микроорганизмы - или микробы - это собирательный термин, включающий все живые существа, которых невозможно увидеть невооруженным глазом. К ним относятся различные грибы, водоросли и простейшие, но прежде всего бактерии и археи. Последние представляют собой простейшие, отличающиеся от бактерий по ряду признаков и образующие в системе живых существ свой домен. Когда ученые в просторечии говорят о бактериях, они часто подразумевают археи, и Гилберт тоже. Вирусы лишь изредка относят к микроорганизмам, потому что их обычно считают пограничным случаем жизни: у них нет метаболизма и они не могут воспроизводиться самостоятельно. Подводя итог, можно сказать, что объект исследования Гилберта и его коллег крошечный, живой, вездесущий и обычно даже не имеет клеточного ядра..
"Конечно, это невозможно, но это не должно нас смущать", - объясняет Гилберт. Он описывает бактерии как необходимые для всей жизни на Земле: «Это фантастические организмы, способные на самые невероятные вещи. Это мельчайшие живые существа, но они оказывают наибольшее влияние на нашу планету». Бактерии формируют нашу иммунную систему. Они перерабатывают питательные вещества и делают их доступными для растений. Они отвечают за метаболизм всех живых существ с клеточным ядром и даже для фотосинтеза - потому что митохондрии и хлоропласты, вероятно, произошли от бактерий. «Без бактерий, - резюмирует Гилберт, - у нас была бы мертвая планета».
Предварительная цель проекта - изучить 200 000 образцов из как можно большего количества разных уголков мира. Несмотря на финансирование, это работает только при поддержке многочисленных волонтеров. «Мы просим исследователей из всех дисциплин: если вы где-то берете образец, немного ущипните его и отправьте нам». Помимо микробиологов, на призыв уже откликнулись зоофизиологи, химики, инженеры, архитекторы и хирурги, которые прислали тампоны, шланги с почвой, воздушные или водные фильтры. А многочисленные университеты и даже частные лица предоставляют свои серверы для огромной вычислительной мощности проекта.
Образцы, присланные со всего мира, относятся к определенным биомам - это сообщества растений и животных, такие как тропический лес. Цель состоит в том, чтобы выяснить, где в мире можно найти определенные микроорганизмы, а также микробиомы. Микробиом - это сообщество микроорганизмов в гораздо меньшей области, например, в человеческом теле. Подобно растениям и животным, микроорганизмы могут взаимодействовать друг с другом. Например, один вид питается другим или оба живут в симбиозе. Более того, их взаимодействие запускает определенные процессы - например, пищеварительная система коровы работает только за счет микробов в ее четырех желудках.
50 000 образцов
Огромный объем данных о распространении позволяет определить, например, условия окружающей среды, при которых одно микробное сообщество сменяется другим. Поэтому Гилберт и его коллеги хотят создать глобальный генный атлас микробов: «Так мы лучше поймем, как устроена планета, сможем лучше использовать ее, а также защитить - чтобы мы могли сохранить ее и самих себя». момент, когда мы не делаем ни одной хорошей работы в этом отношении."
"Если вы где-то возьмете образец, отрежьте немного и пришлите нам" (Джек Гилберт)
Исследователям пришлось сократить некоторые заявления: «Мы не регистрируем грибы, водоросли и простейшие в деталях. А при классификации бактерий и архей мы концентрируемся на семействах». Потому что семейства остаются относительно постоянными - в отличие от видов: любой, кто изучает бактериальный вид сегодня, не знает, скоро ли он мутирует. Чтобы определить это, исследователи в первую очередь анализируют определенный участок генома - 16 S-рибосомную РНК, которая обнаружена у всех бактерий, но немного отличается от вида к виду. Однако они редко расшифровывают весь геном или взаимодействие между отдельными организмами: наиболее важной частью остается таксономия.
Проект рассчитан на шесть лет. В настоящее время исследователи получили около 50 000 образцов из самых разных регионов. Среди них материалы из глубоководных вулканов, соленых озер, снежников в Гималаях, из глубин Антарктиды и даже с Международной космической станции. Ссылка на землю кажется здесь немного надуманной. Но Гилберт смотрит на это прагматично: «Так мы сможем исследовать влияние гравитации на бактерии. На станции также полно людей». Потому что места, активно используемые людьми, и даже дома также представляют интерес для исследователей. Ведь они тоже кусочки пазла большой картины: «Будь то животное или человек, желудок, кожа или нос - мы открыты ко всему и исследуем это», - объясняет микробиолог.

Чрезвычайно специализированный - и чрезвычайно распространенный
На данный момент Гилберту и его коллегам удалось идентифицировать и классифицировать 20 миллионов видов по семействам. Это показывает им, например, какие среды особенно разнообразны: «До сих пор ручьи и малые реки были самыми экстремальными. Вероятно, вся система здесь находится в постоянном изменении, и есть много ниш для бактерий». Распределение организмов также вызывает удивление. Иногда совершенно разные районы имеют сходный микробный состав: «А ранее неизвестный вид очень широко распространен и доминирует - он отсутствует только в действительно экстремальных местах». Возможно, по мнению исследователя, она играет важную роль, которую еще предстоит признать. И, вероятно, у него разный потенциал с точки зрения производительности и продолжительности жизни в каждом месте: «Многие бактерии по-разному адаптировались к разным местам и, таким образом, могут распространяться, но этот - необыкновенный. Правда, результаты не так оглашаются, как открытие гигантского осьминога: «Трудно продавать что-то подобное, когда у бактерии есть только номер».
Все результаты общедоступны на веб-сайте: По словам Гилберта, данные настолько фундаментальны, что каждый должен иметь к ним немедленный доступ. Он считает, что исследования микроорганизмов необходимы для медицины, а также для решения экологических проблем. С нефтяными пятнами в открытом море уже борются микроорганизмы. И Гилберт также надеется лучше понять изменение климата: «В результате глобального потепления многие археи будут производить больше метана и, в свою очередь, интенсифицировать процессы. Мы должны научиться оценивать эти системы, чтобы иметь возможность влиять на них». Гилберт не считает, что результаты могут быть использованы не по назначению - например, для создания нового биологического оружия: «Мы уже знаем большинство организмов, оказывающих смертельное воздействие на человека."
Но работы меньше не становится. Команда все еще анализирует имеющиеся образцы, не говоря уже о тех, которые поступают каждый день. Ученые часто сравнивают необходимость исследований в области микроорганизмов с темной материей космоса: «Мы знаем очень много, - говорит Гилберт, - и в то же время совсем ничего». Тем не менее, он настроен оптимистично: «Наше невежество огромно, но так же велика и наша способность к исследованиям».
Шестилетний грант почти закончился - Гилберт, Янссон и Найт должны подать заявку на новые гранты. Но Гилберт продолжал бы и без субсидий: «Пока я занимаюсь исследованиями, я буду продолжать повышать уровень нашего проекта с каждым образцом». Если бы Чарльз Дарвин был жив сегодня, он был бы микробиологом, говорит Гилберт. Он видит в регистрации микроорганизмов значительную веху, аналогичную обширным дарвиновским классификациям животных и растений: «И тут появилось нечто весьма важное - теория естественного отбора."
